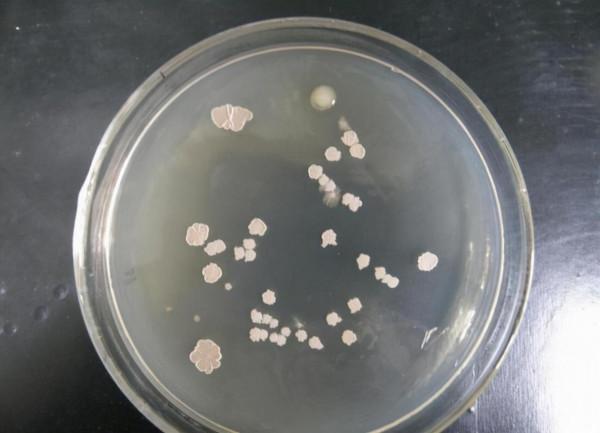
為永保青春，科學家與女模一起注射350萬年前細菌，後來如何？

人類科學發展到今天已經創造了許多奇蹟,但是面對長生不老這個夢想依然是無能為力。當然也正是因為未能解決,目前依然有很多科學家將長生不老當做他們的研究重點。據悉,有一名叫做阿納託利.布勞奇科夫的國外科學家,為永保青春曾與女模一起注射350萬年前細菌。那麼,後來如何了呢?
意外發現上古病毒
這位科學家來自於澳大利亞州立大學,他在2009年的時候,在西伯利亞地帶發現了一具儲存2000多年的猛獁象屍體。大象的屍體儲存在凍土層當中,發現的時候依然完好,因此這具屍體也擁有了非比尋常的研究價格。布勞奇科夫是研究團隊的核心人物,他負責解剖大象的大腦,最後從大腦當中發現了來自於350萬年前的細菌,並將其命名為芽孢桿菌F。緊接著他又對這個芽孢桿菌進行深入研究,最後發現這種病毒有極強的適應能力與繁殖能力,還會產生某種抗菌物質。他試著將病毒注入小鼠體內,結果發現小老鼠恢復了生育能力。最後一位流行病學家推測,也許是這種病毒進入生物體內之後,會釋放活性物質,最後激發生物的細胞免疫狀態,以達到啟用細胞以及延長壽命的目的。
長生不老試驗
隨後,這位科學家對發現猛獁象的周邊地區進行了調查,他發現凍土帶因為氣溫在逐漸融化,很多細菌隨著水源流入人們的飲水系統,而生活在當地的雅庫特人在壽命上明顯優於其他人類。加上這一點新發現,這位科學家作出了更大膽的決定,他打算將發現的細菌注入自己體內,讓自己成為一個實驗品。
注射之後發生了什麼?
為了證明細菌有延年益壽的能耐,布勞奇科夫於2013年完成了主攝,隨後對自己又進行了很長時間的觀察。兩年以後,這位科學家給出了一個說明,他表示身體似乎沒發生什麼異常,比起之前感冒的情況少了很多,看上去自己的免疫力有所增強。但是單一的實驗個體並不能說明所有問題,因為其中偶然因素太多,否則在科學研究當中就沒有必要講究樣本的數量了。於是在這位研究人員的說服之下,找到了一名來自於德國的45歲女模特,並且向這位模特體內注入了芽孢桿菌F。最後一次更新實驗資料於2019年,自此之後杳無音信。
結語
假設這種來自於450萬年前的細菌有延年益壽的能力,但如果想要實現長生不老,依然是遙不可及。基因科學家已經有明確的發現,人的壽命與細胞的分裂次數密切相關。基於這一發現,人類可以延長壽命的方法只有兩種,第1種方式是提高DNA端粒的長度,這些DNA能夠滿足所有細胞的理想分裂次數。第2種方式則是指望端粒酶做出改變,進而改變DNA的長度,以此改變人們平均的壽命。根據現有的兩位實驗人員發現,這種遠古細菌似乎只能提高人們的身體抵抗能力,透過這種方式最後延長了人們的壽命,但從DNA層面來考慮,並沒有做出任何改變,這也意味著指望靠其實現長生不老,依然是天方夜譚。